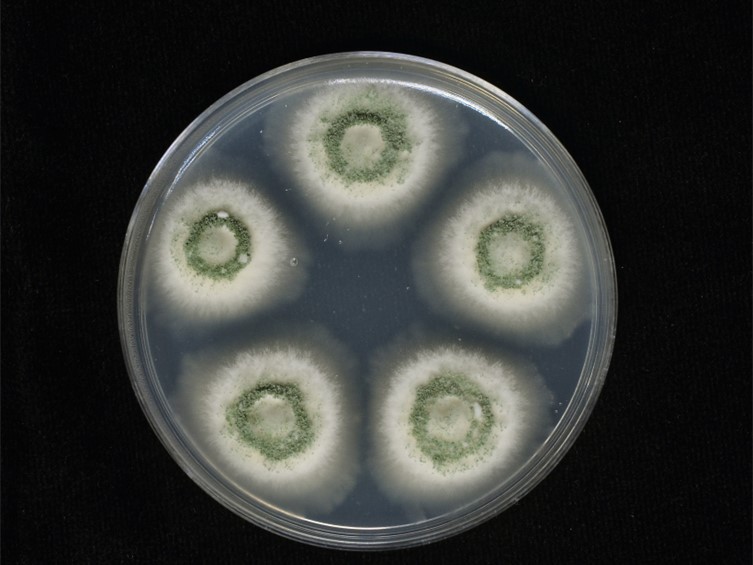

Holotype:
THAILAND, Phetchaburi Province, Kaeng Krachan National Park, 28 Sep. 2000, A. Lathisungnoen, R. Nasit, W. Chaygate, holotype BBH 8129, ex-type living culture BCC 7600.
Habitat:
Underside of leaves.
Host:
Adult mosquitoes (Diptera; Culicidae).
Description:
 Host covered with lime-green powdery
Host covered with lime-green powdery  conidia.
conidia.  Phialides smooth-walled, ovoid with semi-papillate apices, 6-11 × 2-3 μm. Conidia smooth-walled, lime-green, fusiform-elliptical, 5-8 × 1.5-2 μm.
Phialides smooth-walled, ovoid with semi-papillate apices, 6-11 × 2-3 μm. Conidia smooth-walled, lime-green, fusiform-elliptical, 5-8 × 1.5-2 μm.
Culture characteristics:
Colonies on PDA attaining a diam of 22–24 mm in 20 d, dense mycelium, floccose, slightly convex to the agar surface, white turning to parrot-green, powdery while sporulating. Sporulation starts at 7 d after inoculation, reverse tawny olive in the middle of colony and white cream at the margin. Conidiophores arising from aerial mycelium, erect, smooth-walled, cylindrical. Phialides smooth-walled, cylindrical with semi-papillate apices, 6–10 × 2–3 μm. Conidia smooth-walled, parrot-green, fusiform-elliptical, 5–8 × 1.5–2 μm.
Colonies on PDA attaining a diam of 22–24 mm in 20 d, dense mycelium, floccose, slightly convex to the agar surface, white turning to parrot-green, powdery while sporulating. Sporulation starts at 7 d after inoculation, reverse tawny olive in the middle of colony and white cream at the margin. Conidiophores arising from aerial mycelium, erect, smooth-walled, cylindrical. Phialides smooth-walled, cylindrical with semi-papillate apices, 6–10 × 2–3 μm. Conidia smooth-walled, parrot-green, fusiform-elliptical, 5–8 × 1.5–2 μm.
Reference:
Mongkolsamrit S, Khonsanit A, Thanakitpipattana D, et al. (2020). Revisiting Metarhizium and the description of new species from Thailand. Studies in Mycology 95: 171–251.
DOI: https://doi.org/10.1016/j.simyco.2020.04.001Species |
Strain |
Compound |
Pubchem CID |
Biological activity |
Reference |
|---|
|
Strain |
ITS | LSU | RPB1 | RPB2 | SSU | TEF1 |
|---|---|---|---|---|---|---|
| BCC 2673 | MN781887 | MN781851 | MN781753 | MN781802 | MN781950 | MN781706 |
| BCC 7600 | MN781889 | MN781852 | MN781754 | MN781803 | MN781951 | - |
| BCC 7625 | MN781888 | MN781850 | MN781801 | - | - |